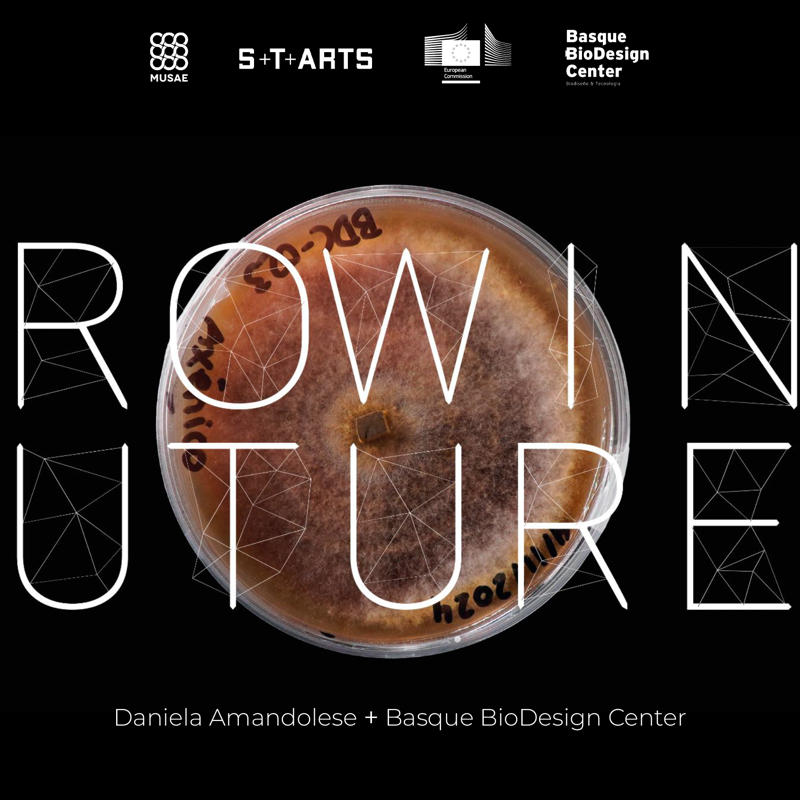
Diseño de Interacción

UNA PLATAFORMA PARA MENTES CREATIVAS
Selekted Bilbao-Bizkaia
Selekted es un espacio para inspirar y compartir nuevas ideas. Una comunidad abierta a las mentes creativas. Nuestra plataforma digital conecta: proyectos, perfiles y conferencias.
¡Anímate y participa!
Call for Entries
Ya está abierta la convocatoria de proyectos creativos. Comparte tu trabajo para participar en la edición 2026.
Comunidad creativa
Los campos creativos cada vez se encuentran más interconectados. Descubre creatividad y nuevas ideas en comunidad.
Plataforma digital
selekted.net es un punto de encuentro para mentes creativas que conecta proyectos, perfiles y conferencias creativas.
Evento Bilbao-Bizkaia
Se ha confirmado el evento presencial para esta temporada 2026. Reserva el mes de noviembre... ¡Tendremos novedades!